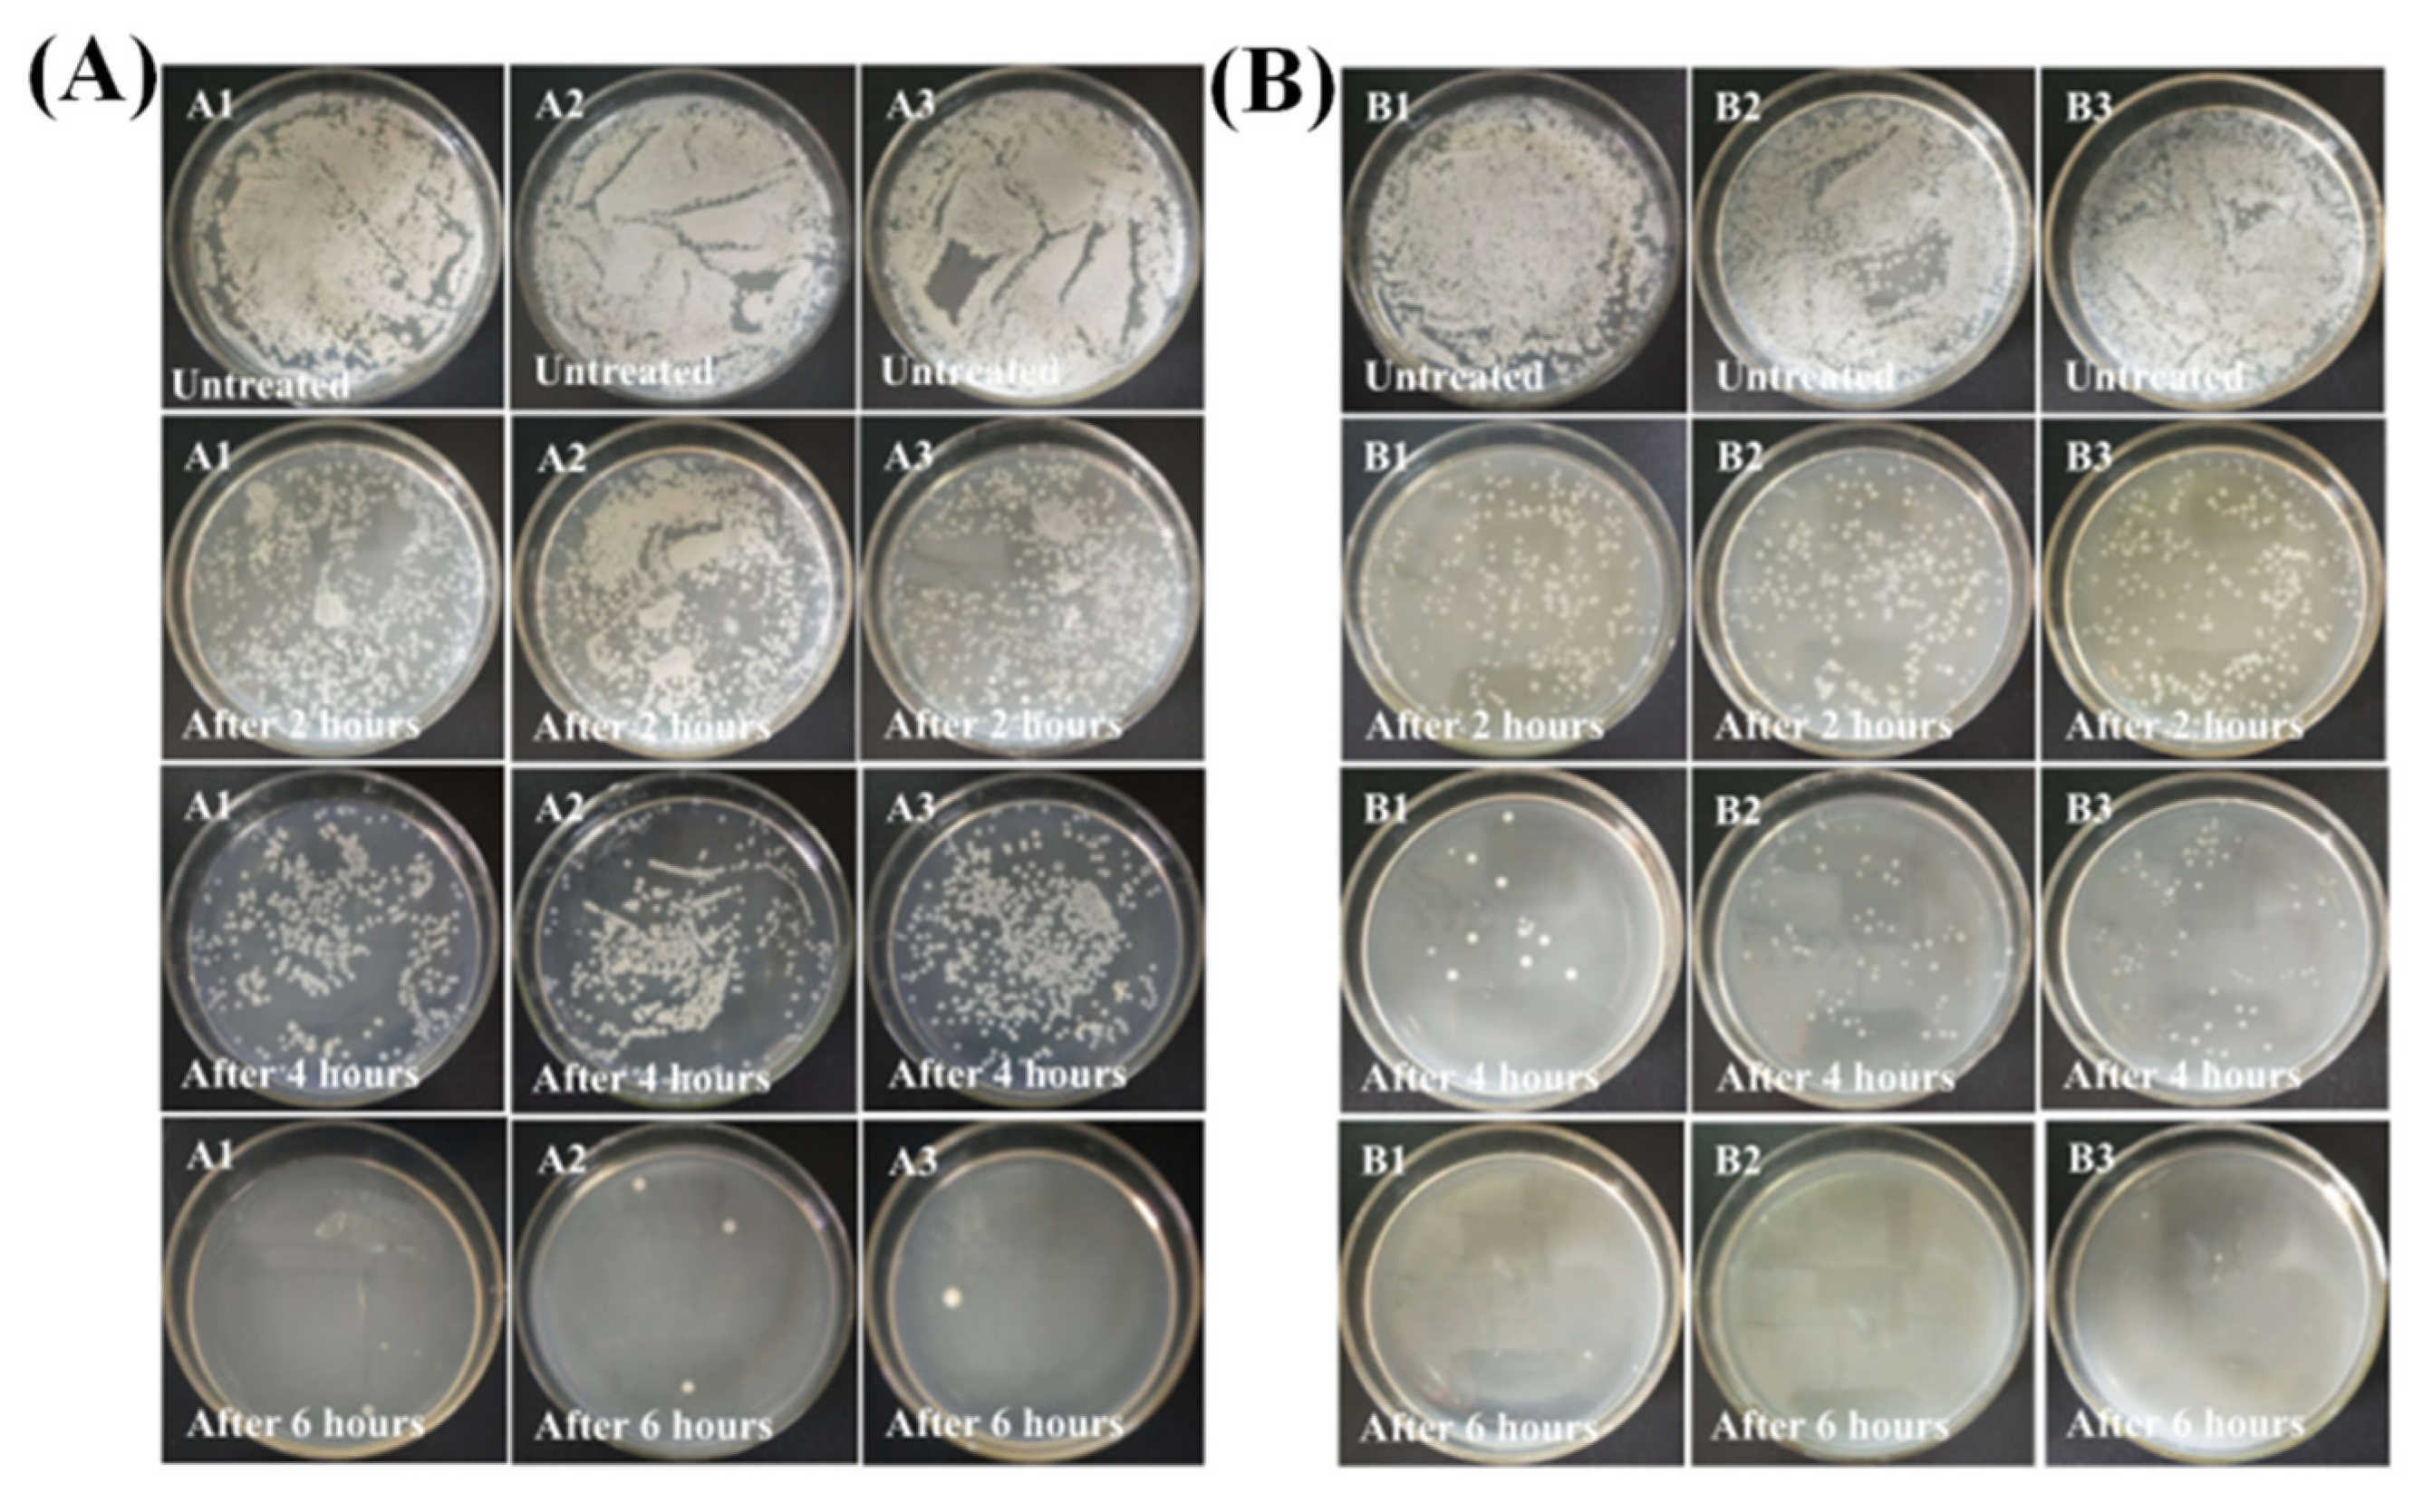
Ijms 23 09651 g005

A Nickel-Containing Polyoxomolybdate as an Efficient Antibacterial Agent for Water Treatment
Abstract
:1. Introduction
2. Results and Discussion
2.1. Antibacterial Properties
2.2. Time-Kill Studies
2.3. Adsorption Performances
2.3.1. Adsorption Kinetics
2.3.2. Equilibrium Results
2.4. Probable Action Mechanisms
3. Materials and Methods
3.1. Materials
3.2. Preparation of 1
4. Conclusions
Supplementary Materials
Author Contributions
Funding
Institutional Review Board Statement
Informed Consent Statement
Data Availability Statement
Conflicts of Interest
References
- Qi, K.; Cheng, B.; Yu, J.; Ho, W. Review on the improvement of the photocatalytic and antibacterial activities of ZnO. J. Alloy. Compd. 2017, 727, 792–820. [Google Scholar] [CrossRef]
- Fang, J.; Chen, Y.; Fang, C.; Zhu, L. Regenerable adsorptive membranes prepared by mussel-inspired co-deposition for aqueous dye removal. Sep. Purif. Technol. 2022, 281, 119876. [Google Scholar] [CrossRef]
- Badvi, K.; Javanbakht, V. Enhanced photocatalytic degradation of dye contaminants with TiO2 immobilized on ZSM-5 zeolite modified with nickel nanoparticles. J. Clean. Prod. 2021, 280, 124518. [Google Scholar] [CrossRef]
- Cao, M.; Wang, S.; Hu, J.; Lu, B.; Wang, Q.; Zang, S. Silver Cluster-Porphyrin-Assembled Materials as Advanced Bioprotective Materials for Combating Superbacteria. Adv. Sci. 2022, 9, 2103721. [Google Scholar] [CrossRef]
- Asad, M.; Wang, S.; Wang, Q.-Y.; Li, L.-K.; Anwar, M.I.; Younas, A.; Zang, S.-Q. Aqueous media ultra-sensitive detection of antibiotics via highly stable luminescent 3D Cadmium-based MOF. New J. Chem. 2021, 45, 20887–20894. [Google Scholar] [CrossRef]
- Xing, C.; Chang, J.; Ma, M.; Ma, P.; Sun, L.; Li, M. Ultrahigh-efficiency antibacterial and adsorption performance induced by copper-substituted polyoxomolybdate-decorated graphene oxide nanocomposites. J. Colloid Interface Sci. 2022, 612, 664–678. [Google Scholar] [CrossRef]
- Leng, B.; Zhang, X.L.; Chen, S.S.; Li, J.; Sun, Z.Q.; Ma, Z.Y.; Yang, W.J.; Zhang, B.C.; Yang, K.; Guo, S. Highly efficient visible-light photocatalytic degradation and antibacterial activity by GaN:ZnO solid solution nanoparticles. J. Mater. Sci. Technol. 2021, 94, 67–76. [Google Scholar] [CrossRef]
- Ye, W.T.; Jiang, Y.; Liu, Q.; Xu, D.D.; Zhang, E.; Cheng, X.W.; Wan, Z.; Liu, C. The preparation of visible light-driven ZnO/Ag2MoO4/Ag nanocomposites with effective photocatalytic and antibacterial activity. J. Alloy. Compd. 2021, 891, 161898. [Google Scholar] [CrossRef]
- Lv, C.; Chen, S.; Xie, Y.; Wei, Z.; Chen, L.; Bao, J.; He, C.; Zhao, W.; Sun, S.; Zhao, C. Positively-charged polyethersulfone nanofibrous membranes for bacteria and anionic dyes removal. J. Colloid Interface Sci. 2019, 556, 492–502. [Google Scholar] [CrossRef]
- Xu, Y.T.; Lin, W.T.; Wang, H.; Guo, J.B.; Yuan, D.D.; Bao, J.X.; Sun, S.D.; Zhao, W.F.; Zhao, C.S. Dual-functional polyethersulfone composite nanofibrous membranes with synergistic adsorption and photocatalytic degradation for organic dyes. Compos. Sci. Technol. 2020, 199, 108353. [Google Scholar] [CrossRef]
- Yadav, A.; Sharma, A.; Sharma, R.K. Mesoporous iron gallate nanocomplex for adsorption and degradation of organic dyes. Colloids Surf. A Physicochem. Eng. Asp. 2019, 579, 123694. [Google Scholar] [CrossRef]
- Kong, Q.; Li, Z.G.; Ding, F.; Ren, X.H. Hydrophobic N-halamine based POSS block copolymer porous films with anti-bacterial and resistance of bacterial adsorption performances. Chem. Eng. J. 2021, 410, 128407. [Google Scholar] [CrossRef]
- Malwal, D.; Gopinath, P. Efficient adsorption and antibacterial properties of electrospun CuO-ZnO composite nanofibers for water remediation. J. Hazard. Mater. 2017, 321, 611–621. [Google Scholar] [CrossRef] [PubMed]
- Liu, Y.L.; Jia, J.; Gao, T.T.; Wang, X.L.; Yu, J.Y.; Wu, D.Q.; Li, F.X. One-pot fabrication of antibacterial beta-cyclodextrin-based nanoparticles and their superfast, broad-spectrum adsorption towards pollutants. J. Colloid Interface Sci. 2020, 576, 302–312. [Google Scholar] [CrossRef]
- Li, J.F.; Chen, Z.J.; Zhou, M.C.; Jing, J.B.; Li, W.; Wang, Y.; Wu, L.X.; Wang, L.Y.; Wang, Y.Q.; Lee, M. Polyoxometalate-driven self-assembly of short peptides into multivalent nanofibers with enhanced antibacterial activity. Angew. Chem. Int. Ed. 2016, 55, 2592–2595. [Google Scholar] [CrossRef]
- Liu, J.-X.; Zhang, X.-B.; Li, Y.-L.; Huang, S.-L.; Yang, G.-Y. Polyoxometalate functionalized architectures. Coord. Chem. Rev. 2020, 414, 213260. [Google Scholar] [CrossRef]
- Gumerova, N.I.; Al-Sayed, E.; Krivosudský, L.; Čipčić-Paljetak, H.; Verbanac, D.; Rompel, A. Antibacterial Activity of Polyoxometalates Against Moraxella catarrhalis. Front. Chem. 2018, 6, 336. [Google Scholar] [CrossRef]
- Zhao, M.; Fang, Y.; Ma, L.; Zhu, X.; Jiang, L.; Li, M.; Han, Q. Synthesis, characterization and in vitro antibacterial mechanism study of two Keggin-type polyoxometalates. J. Inorg. Biochem. 2020, 210, 111131. [Google Scholar] [CrossRef]
- Tanuhadi, E.; Gumerova, N.I.; Prado-Roller, A.; Galanski, M.; Cipcic-Paljetak, H.; Verbanac, D.; Rompel, A. Aluminum-substituted Keggin germanotungstate [HAl(H2O)GeW11O39]4− synthesis, characterization, and antibacterial activity. Inorg. Chem. 2021, 60, 28–31. [Google Scholar] [CrossRef]
- Yao, L.; Zhang, L.; Wang, R.; Chou, S.; Dong, Z. A new integrated approach for dye removal from wastewater by polyoxometalates functionalized membranes. J. Hazard. Mater. 2016, 301, 462–470. [Google Scholar] [CrossRef]
- Lesbani, A.; Taher, T.; Palapa, N.R.; Mohadi, R.; Rachmat, A. Mardiyanto Preparation and utilization of Keggin-type polyoxometalate intercalated Ni–Fe layered double hydroxides for enhanced adsorptive removal of cationic dye. SN Appl. Sci. 2020, 2, 1–4. [Google Scholar] [CrossRef]
- Misra, A.; Castillo, I.F.; Müller, D.P.; González, C.; Eyssautier-Chuine, S.; Ziegler, A.; De La Fuente, J.M.; Mitchell, S.G.; Streb, C. Back Cover: Polyoxometalate-Ionic Liquids (POM-ILs) as Anticorrosion and Antibacterial Coatings for Natural Stones (Angew. Chem. Int. Ed. 45/2018). Angew. Chem. Int. Ed. 2018, 57, 14948. [Google Scholar] [CrossRef]
- Bijelic, A.; Aureliano, M.; Rompel, A. The antibacterial activity of polyoxometalates: Structures, antibiotic effects and future perspectives. Chem. Commun. 2018, 54, 1153–1169. [Google Scholar] [CrossRef] [PubMed]
- Xing, C.L.; Ma, P.T.; Zhao, M.; Chang, J.N.; Guo, X.Y.; Sun, L.; Li, M.X. Facile and green synthesis of decatungstate-based nickel(ii) complex coated onto modified Fe3O4 nanoparticles with enhanced antimicrobial activity against antibiotic-resistant bacteria. CrystEngComm 2021, 23, 3919–3928. [Google Scholar] [CrossRef]
- King, A.P.; Gellineau, H.A.; Ahn, J.E.; MacMillan, S.N.; Wilson, J.J. Bis(thiosemicarbazone) complexes of cobalt(III): Synthesis, characterization, and anticancer potential. Inorg. Chem. 2017, 56, 6609–6623. [Google Scholar] [CrossRef]
- Li, M.-X.; Chen, C.-L.; Ling, C.-S.; Zhou, J.; Ji, B.-S.; Wu, Y.-J.; Niu, J.-Y. Cytotoxicity and structure–activity relationships of four α-N-heterocyclic thiosemicarbazone derivatives crystal structure of 2-acetylpyrazine thiosemicarbazone. Bioorganic Med. Chem. Lett. 2009, 19, 2704–2706. [Google Scholar] [CrossRef]
- Li, J.; Wang, B.; Chang, B.; Liu, J.; Zhu, X.; Ma, P.; Sun, L.; Li, M. One new hexatungstate-based binuclear nickel(II) complex with high selectivity adsorption for organic dyes. J. Mol. Struct. 2021, 1231, 129674. [Google Scholar] [CrossRef]
- Dolomanov, O.V.; Bourhis, L.J.; Gildea, R.J.; Howard, J.A.K.; Puschmann, H. OLEX2: A complete structure solution, refinement and analysis program. J. Appl. Cryst. 2009, 42, 339–341. [Google Scholar] [CrossRef]
- Sheldrick, G.M. SHELXT–integrated space-group and crystalstructure determination. Acta Cryst. 2015, A71, 3–8. [Google Scholar]
- Casanova, D.; Llunell, M.; Alemany, P.; Alvarez, S. The Rich Stereochemistry of Eight-Vertex Polyhedra: A Continuous Shape Measures Study. Chem. A Eur. J. 2005, 11, 1479–1494. [Google Scholar] [CrossRef]
- Tian, A.; Ning, Y.; Ying, J.; Zhang, J.; Hou, X.; Li, T.; Wang, X. Highly efficient usage of the hydrothermal technique through the one-pot method to construct four Keggin-based compounds containing pendent ligands. Dalton Trans. 2015, 44, 10499–10507. [Google Scholar] [CrossRef] [PubMed]
- Alizadeh, M.H.; Holman, K.T.; Mirzaei, M.; Razavi, H. Triprolinium 12-phosphomolybdate: Synthesis, crystal structure and properties of [C5H10NO2]3[PMo12O40]·4.5H2O. Polyhedron 2019, 2, 5898–5904. [Google Scholar] [CrossRef]
- Wang, J.; Chen, Y.; Cheng, N.; Feng, L.; Gu, B.-H.; Liu, Y. Multivalent Supramolecular Self-Assembly between β-Cyclodextrin Derivatives and Polyoxometalate for Photodegradation of Dyes and Antibiotics. ACS Appl. Bio Mater. 2019, 2, 5898–5904. [Google Scholar] [CrossRef] [PubMed]
- Soares, J.C.S.; Gonçalves, A.H.A.; Zotin, F.M.; de Araújo, L.R.R.; Gaspar, A.B. Cyclohexene to adipic acid synthesis using heterogeneous polyoxometalate catalysts. Mol. Catal. 2018, 458, 223–229. [Google Scholar] [CrossRef]
- Yasmina, I.; Sihem, M.; Dahbia, A.; Tassadit, M.; Catherine, M.-R.; Cherifa, R. Cyclohexanone oxidation over H3PMo12O40 heteropolyacid via two activation modes microwave irradiation and conventional method. Bull. Chem. React. Eng. 2019, 14, 427–435. [Google Scholar]
- Tai, Y.-X.; Ji, Y.-M.; Lu, Y.-L.; Li, M.-X.; Wu, Y.-Y.; Han, Q.-X. Cadmium(II) and indium(III) complexes derived from 2-benzoylpyridine N(4)-cyclohexylthiosemicarbazone: Synthesis, crystal structures, spectroscopic characterization and cytotoxicity. Synth. Met. 2016, 219, 109–114. [Google Scholar] [CrossRef]
- Tan, F.; Chen, H.; Yuan, R.; Zhang, X.; Chen, D. Co-Ni Basic Carbonate Nanowire/Carbon Nanotube Network With High Electrochemical Capacitive Performance via Electrochemical Conversion. Front. Chem. 2021, 9, 655025. [Google Scholar] [CrossRef]
- Yu, J.G.; Hai, Y.; Cheng, B. Enhanced photocatalytic H2-production activity of TiO2 by Ni(OH)2 cluster modification. J. Phys. Chem. C 2011, 115, 4953–4958. [Google Scholar] [CrossRef]
- Haddad, M.E. Removal of Basic Fuchsin dye from water using mussel shell biomass waste as an adsorbent: Equilibrium, kinetics, and thermodynamics. J. Taibah. Univ. Sci. 2016, 10, 664–674. [Google Scholar] [CrossRef]
- Xiong, W.P.; Zeng, Z.; Zeng, G.; Yang, Z.; Xiao, R.; Li, X.; Cao, J.; Zhou, C.; Chen, H.; Jia, M.; et al. Metal-organic frameworks derived magnetic carbon-αFe/Fe3C composites as a highly effective adsorbent for tetracycline removal from aqueous solution. Chem. Eng. J. 2019, 374, 91–99. [Google Scholar] [CrossRef]
- Tao, E.; Ma, D.; Yang, S.Y.; Hao, X. Graphene oxide-montmorillonite/sodium alginate aerogel beads for selective adsorption of methylene blue in wastewater. J. Alloy. Compd. 2020, 832, 154833. [Google Scholar]
- He, R.; Xue, K.; Wang, J.; Yan, Y.; Peng, Y.; Yang, T.; Hu, Y.; Wang, W. Nitrogen-deficient g-C3Nx/POMs porous nanosheets with P–N heterojunctions capable of the efficient photocatalytic degradation of ciprofloxacin. Chemosphere 2020, 259, 127465. [Google Scholar] [CrossRef]
- Li, J.; Si, C.; Zhao, H.; Meng, Q.; Chang, B.; Li, M.; Liu, H. Dyes Adsorption Behavior of Fe3O4 Nanoparticles Functionalized Polyoxometalate Hybrid. Molecules 2019, 24, 3128. [Google Scholar] [CrossRef] [PubMed] [Green Version]
- Cheng, X.; Sun, P.; Zhang, S.; Sun, D.; Jiang, B.; Wang, W.; Xin, X. Self-assembly of m-phenylenediamine and polyoxometalate into hollow-sphere and core-in-hollow-shell nanostructures for selective adsorption of dyes. J. Mol. Liq. 2019, 287, 110982. [Google Scholar] [CrossRef]
- Wei, R.; Song, W.Y.; Yang, F.; Zhou, J.K.; Zhang, M.; Zhang, X.; Zhao, W.F.; Zhao, C.S. Bidirectionally pH-responsive zwitterionic polymer hydrogels with switchable selective adsorption capacities for anionic and cationic dyes. Ind. Eng. Chem. Res. 2018, 57, 8209–8219. [Google Scholar] [CrossRef]
- Fang, Y.; Xing, C.; Zhan, S.; Zhao, M.; Li, M.; Liu, H. A polyoxometalate-modified magnetic nanocomposite: A promising antibacterial material for water treatment. J. Mater. Chem. B 2019, 7, 1933–1944. [Google Scholar] [CrossRef]
- Li, X.; Sun, J.; Che, Y.; Lv, Y.; Liu, F. Antibacterial properties of chitosan chloride-graphene oxide composites modified quartz sand filter media in water treatment. Int. J. Biol. Macromol. 2019, 121, 760–773. [Google Scholar] [CrossRef]
- Chen, C.Z.; Cooper, S.L. Interactions between dendrimer biocides and bacterial membranes. Biomaterials. 2002, 23, 3359–3368. [Google Scholar] [CrossRef]
- He, M.Y.; Wu, T.; Pan, S.Y.; Xu, X.Y. Antimicrobial mechanism of flavonoids against Escherichia coli ATCC 25922 by model membrane study. Appl. Surf. Sci. 2014, 305, 515–521. [Google Scholar] [CrossRef]
- Liu, S.B.; Zeng, T.Y.H.; Hofmann, M.; Burcombe, E.; Wei, J.; Jiang, R.R.; Kong, J.; Chen, Y. Antibacterial activity of graphite, graphite oxide, graphene oxide, and reduced graphene oxide: Membrane and oxidative stress. ACS Nano 2011, 5, 6971–6980. [Google Scholar] [CrossRef]
- Zhang, M.Z.; Zhang, C.; Zhai, X.Y.; Luo, F.; Du, Y.P.; Yan, C.H. Antibacterial mechanism and activity of cerium oxide nanoparticles. Sci China Mater. 2019, 62, 1727–1739. [Google Scholar] [CrossRef]
- Banerjee, M.; Mallick, S.; Paul, A.; Chattopadhyay, A.; Ghosh, S.S. Heightened reactive oxygen species generation in the antimicrobial activity of a three component iodinated chitosan-silver nanoparticle composite. Langmuir 2010, 26, 5901–5908. [Google Scholar] [CrossRef] [PubMed]
- Riener, C.K.; Kada, G.; Gruber, H.J. Quick measurement of protein sulfhydryls with Ellman’s reagent and with 4,4′-dithiodipyridine. Anal Bioanal. Chem. 2002, 373, 266–276. [Google Scholar] [CrossRef] [PubMed]
- Mukherjee, S.; Chowdhury, D.; Kotcherlakota, R.; Patra, S.; Vinothkumar, B.; Bhadra, M.P.; Sreedhar, B.; Patra, C.R. Potential Theranostics Application of Bio-Synthesized Silver Nanoparticles (4-in-1 System). Theranostics 2014, 4, 316–335. [Google Scholar] [CrossRef]
- Sami, P.; Anand, T.D.; Premanathan, M.; Rajasekaran, K. Vanadium(V)-substituted Keggin-type heteropolyoxotung-stophosphates as electron transfer and antimicrobial agents: Oxidation of glutathione and sensitization of MRSA to-wards β-lactam antibiotics. Transit. Metal. Chem. 2010, 35, 1019–1025. [Google Scholar] [CrossRef]
- Soares, S.S.; Martins, H.; Duarte, R.O.; Moura, J.J.G.; Coucelo, J.; Gutiérrez-Merino, C.; Aureliano, M. Vanadium distribution, lipid peroxidation and oxidative stress markers upon decavanadate in vivo administration. J. Inorg. Biochem. 2007, 101, 80–88. [Google Scholar] [CrossRef] [Green Version]

| Microorganism | MIC (µg/mL) | |||||
|---|---|---|---|---|---|---|
| HL | Ni(ClO4)2·6H2O | H3[PMo12O40] | 1 | Am | Kan | |
| E. coli | 0.23 | 31.25 | 0.48 | 0.015 | 0.90 | 7.80 |
| A. tumefaciens | 0.45 | 125.00 | 0.90 | 0.24 | 3.90 | 1.90 |
| B. subtilis | 0.12 | 15.60 | 0.90 | 0.030 | 0.24 | 0.24 |
| S. aureus | 0.12 | 7.80 | 0.12 | 0.0019 | 0.24 | 0.48 |
| Pseudo-First-Order | Pseudo-Second-Order | The Elovich Equation | ||||
|---|---|---|---|---|---|---|
| Concentrations | K | R2 | K | R2 | K | R2 |
| 0.2 mg/mL | −0.03905 | 0.51277 | 0.03769 | 0.99921 | 0.5777 | 0.66326 |
| 0.4 mg/mL | −0.05034 | 0.88066 | 0.03231 | 0.99896 | 2.3566 | 0.98221 |
| 0.8 mg/mL | −0.04577 | 0.90885 | 0.03665 | 0.99697 | 2.9195 | 0.95618 |
| Langmuir Isotherm Model | Freundlich Isotherm Model | Dubbin–Radushkevich Isotherm Model | Temkin Model | |||||
|---|---|---|---|---|---|---|---|---|
| K | R2 | K | R2 | K | R2 | K | R2 | |
| BF | 0.01451 | 0.6249 | 0.82337 | 0.95106 | −2.67931 × 10−6 | 0.85368 | 10.87912 | 0.92921 |
Publisher’s Note: MDPI stays neutral with regard to jurisdictional claims in published maps and institutional affiliations. |
© 2022 by the authors. Licensee MDPI, Basel, Switzerland. This article is an open access article distributed under the terms and conditions of the Creative Commons Attribution (CC BY) license (https://creativecommons.org/licenses/by/4.0/).
Share and Cite
Chang, J.; Li, M.; Du, J.; Ma, M.; Xing, C.; Sun, L.; Ma, P. A Nickel-Containing Polyoxomolybdate as an Efficient Antibacterial Agent for Water Treatment. Int. J. Mol. Sci. 2022, 23, 9651. https://doi.org/10.3390/ijms23179651
Chang J, Li M, Du J, Ma M, Xing C, Sun L, Ma P. A Nickel-Containing Polyoxomolybdate as an Efficient Antibacterial Agent for Water Treatment. International Journal of Molecular Sciences. 2022; 23(17):9651. https://doi.org/10.3390/ijms23179651
Chicago/Turabian StyleChang, Jiangnan, Mingxue Li, Jiyuan Du, Min Ma, Cuili Xing, Lin Sun, and Pengtao Ma. 2022. "A Nickel-Containing Polyoxomolybdate as an Efficient Antibacterial Agent for Water Treatment" International Journal of Molecular Sciences 23, no. 17: 9651. https://doi.org/10.3390/ijms23179651
APA StyleChang, J., Li, M., Du, J., Ma, M., Xing, C., Sun, L., & Ma, P. (2022). A Nickel-Containing Polyoxomolybdate as an Efficient Antibacterial Agent for Water Treatment. International Journal of Molecular Sciences, 23(17), 9651. https://doi.org/10.3390/ijms23179651

